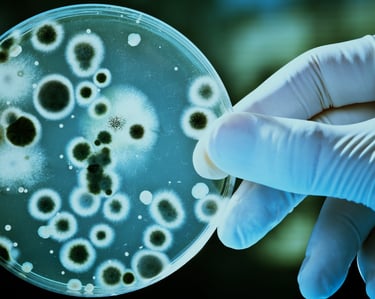
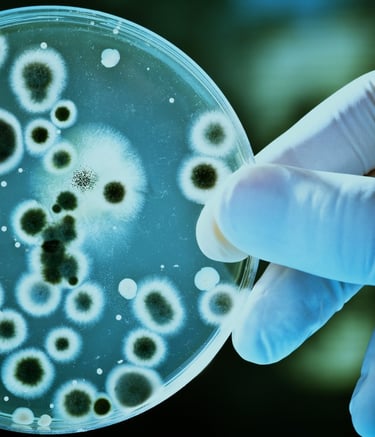
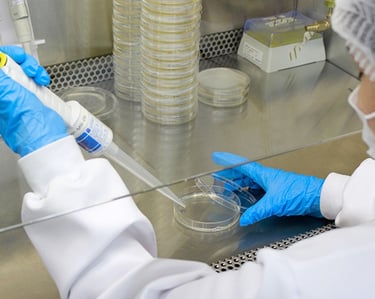
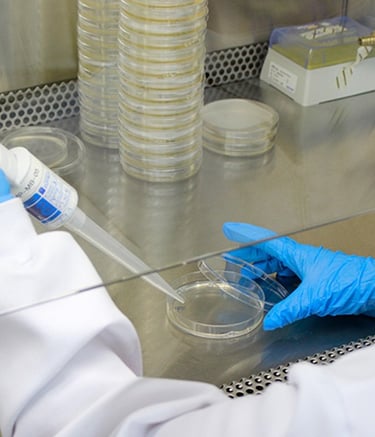
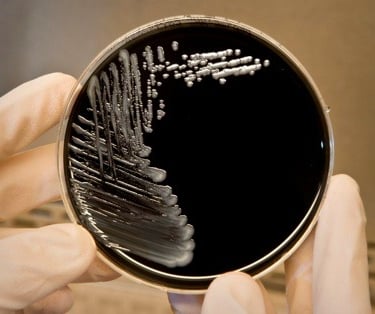

Nossos Serviços
Análises químicas e biológicas com excelência e eficiência para garantir a qualidade dos resultados.
Análise de Legionella
Realizamos análises de Legionella para garantir a segurança da água em ambientes climatizados.


Qualidade do Ar
Oferecemos serviços de análise da qualidade do ar interior, assegurando ambientes saudáveis e seguros.


Legionella em sistemas de condicionamento de ar
A legionella pneumophila é a bactéria responsável pela doença do legionário, que pode afetar gravemente o sistema respiratório. Ela é especialmente perigosa em ambientes onde possa ocorrer a pulverização de água, como em bandejas coletoras de água de sistemas de ar-condicionado e torres de arrefecimento.
A AMB realiza análises para pesquisa de legionella em águas de bandejas coletoras com base na NBR ISO 11731:98.
Nossos Serviços
Análises químicas e biológicas com excelência e qualidade garantida.

Qualidade do Ar Interior em Ambientes Climatizados
Monitoramos e analisamos a qualidade do ar em ambientes climatizados, identificando contaminantes como mofo, bactérias e partículas nocivas. Ideal para empresas, hospitais e escolas que buscam ambientes saudáveis e produtivos.
Benefícios:
Redução de problemas respiratórios.
Melhoria no bem-estar e produtividade.
Conformidade com normas vigentes.

Análises de Laboratório
Realizamos análises laboratoriais precisas para avaliar a qualidade de diferentes amostras, garantindo segurança e conformidade com normas técnicas. Nossos serviços são fundamentais para empresas que buscam cumprir regulamentações e oferecer ambientes mais seguros.
Benefícios:
Garantia de resultados confiáveis.
Adequação a padrões regulatórios.
Suporte para a saúde pública e ambiental.

Legionella
Oferecemos análises especializadas para detectar a presença da bactéria Legionella, causadora da Doença dos Legionários, em sistemas de água. Este serviço é essencial para edifícios comerciais e industriais.
Benefícios:
Prevenção de surtos de doenças graves.
Cumprimento de regulamentações sanitárias.
Preservação da saúde pública.


Potabilidade da Água
Avaliamos a potabilidade da água, verificando se ela está adequada para consumo humano, atendendo às exigências das autoridades sanitárias.
Benefícios:
Segurança no consumo de água.
Prevenção de doenças de origem hídrica.
Conformidade com padrões de saúde e segurança.


Limpeza de Filtro
A limpeza regular dos filtros evita o acúmulo de impurezas, prolonga a vida útil do equipamento e contribui para a eficiência na purificação da água.
Benefícios:
Remoção dos resíduos contaminantes.
Redução de odores e sabores desagradáveis.
Melhoria na pressão e fluxo de água.


Troca de Refil de Filtro
A substituição periódica do refil garante a qualidade da filtragem, evitando riscos à saúde e assegurando o desempenho ideal do sistema.
Inclui:
Avaliação técnica do filtro.
Remoção segura do refil antigo.
Instalação no novo refil com padrão de qualidade AMB.
Agende sua manutenção preventiva com quem entende do assunto!
Cuidar da água é cuidar da sua saúde!
A qualidade das análises do Laboratório Amb superou minhas expectativas. Recomendo a todos os meus colegas.
João Silva
Serviço excelente e rápido. Fiquei muito satisfeito com a análise da potabilidade da água realizada.
Maria Costa
★★★★★
★★★★★
Links Rápidos
Conecte-se conosco
Contato
